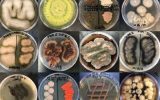

28 октября
-
21:04
В США появился самый маленький дрон. Он весит 249 граммов
 Новости
Новости
-
20:18
Новые роботы-черви могут строить космические корабли
 Новости
Новости
27 октября
-
18:10
Исследование: горные реки поглощают больше углекислого газа, чем леса Амазонки
 Наука
Наука
-
17:06
Появилась первая классификация водных грибов
Наука
Наука
-
16:41
ВВС США будут использовать беспилотные одноразовые самолеты
 Новости
Новости
-
16:18
ИИ научился удалять половину оскорбительных твитов без участия модераторов
 Новости
Новости
-
15:38
Исследование: изменение климата повлияет на наводнения в Европе
 Наука
Наука
-
15:04
Ученые смоделировали события до Большого взрыва
 Наука
Наука
26 октября
-
20:14
Появился проект вечной квантовой батарейки
 Новости
Новости
-
19:44
В Китае приняли закон о криптографии
 Новости
Новости
-
18:15
Нейронная сеть смогла решить задачу трех тел в 100 млн раз быстрее человека
 Наука
Наука
-
17:34
В честь Греты Тунберг назвали жука
 Наука
Наука
-
16:35
Facebook обучил ИИ обманывать системы распознавания лиц
 Новости
Новости
-
15:07
Спутник впервые смог сфотографировать гравитационные волны
 Наука
Наука
25 октября
-
17:17
Горные ручьи производят намного больше углерода, чем предполагали ученые
 Новости
Новости
-
16:31
Китай проанализировал странное вещество, которое нашли на Луне
 Наука
Наука
-
15:08
Осторожно, ваш принтер из будущего: как выглядят инновации в печати
 Партнерский материал
Партнерский материал


